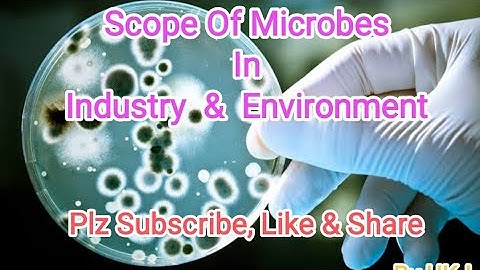
Scope of Microbes in Industry & Environment

⬇ DOWNLOAD NOW
Kalau muncul iklan pop-up, tutup lalu klik tombol kembali
Download lagu Microbiology || B.pharma 3rd sem || UNIT -1|| Introduction , History , Scope , its Importance secara gratis hanya untuk keperluan promosi. Dukung artis favorit kamu dengan membeli musik original di iTunes atau platform resmi lainnya.
 "Top 5 Biochemistry Careers You Should Consider"
"Top 5 Biochemistry Careers You Should Consider"
 Pharmaceutical microbiology
Pharmaceutical microbiology
 history of microbiology portion I: alexander fleming
history of microbiology portion I: alexander fleming
 Difference between prokaryotes and Eukaryotes #shorts #biology #pharmacy #mdcat #cell #youtubeshorts
Difference between prokaryotes and Eukaryotes #shorts #biology #pharmacy #mdcat #cell #youtubeshorts
 Introduction to the core subject of Pharmacy (B.Pharm, D.Pharm)
Introduction to the core subject of Pharmacy (B.Pharm, D.Pharm)
 Transgenic plants
Transgenic plants
 What is Phycology? | Importance of Phycology | Animated Video!
What is Phycology? | Importance of Phycology | Animated Video!
Scope of Microbes in Industry & Environment
Scope of Microbes in Industry & Environment